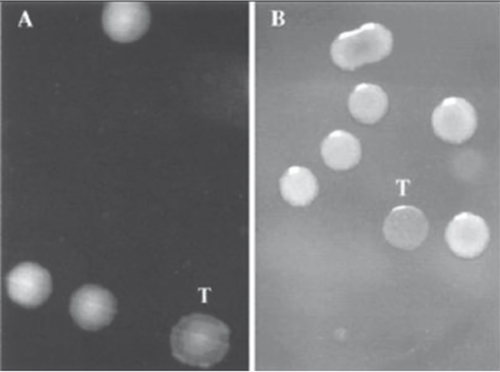

Artículo de Revisión
Deficiencia de anticuerpos con inmunoglobulinas IgA, IgG e IgM normales
Orlei Kantor Junior
ARCHIVOS DE ALERGIA E INMUNOLOGÍA CLÍNICA 2009;( 1):0011-0014 | DOI: 10.53108/AAIC/20091/0011-0014
Objetivos: revisar la deficiencia de anticuerpos con inmunoglobulinas normales que se caracteriza por infecciones bacterianas recurrentes; ausencia o disminución de respuesta para la mayoría de los antígenos polisacáridos; niveles séricos normales o aun poco disminuidos o elevados de inmunoglobulinas y de subclases de IgG y producción de anticuerpos adecuada ante los antígenos proteicos (sarampión, rubéola, etc.) en individuos mayores que 2 años.
Métodos: revisión bibliográfica de 10 años por medio del sistema MEDLINE.
Resultados: se revisaron 68 artículos y se escogieron 41 para ser incluidos en esta revisión.
Conclusiones: estar alerta con los pacientes con infecciones de repetición, principalmente pacientes con infecciones neumocócicas y realizar la evaluación en laboratorio complementaria para un correcto diagnóstico de la enfermedad.
Palabras clave: inmunodeficiencia primaria, deficiencia de anticuerpos, infección neumocócica.
Objectives: To revise antibody deficiency with normal immunoglobulins, which is characterized by recurring bacterial infections; absence or decreased response to the majority of polysaccharide antigens; normal, slightly decreased or increased blood serum levels of immunoglobulins and subclasses IgG; and production of adequate antibodies in the presence of the antigens protein (measles, rubella, etc) in individuals over 2 years of age.
Methods: 10-year bibliographic review, using the MEDLINE system.
Results: 68 articles were revised, of which 41 were selected for inclusion in this review.
Conclusions: Being attentive to patients with repeated infections, particularly patients with pneumococcal infections, and carrying out complementary laboratory evaluation in order to correctly diagnose the disease.
Keywords: primary immunodeficiency, antibody deficiency, pneumococcal infection.
Los autores declaran no poseer conflictos de intereses.
Fuente de información Asociación Argentina de Alergia e Inmunología Clínica. Para solicitudes de reimpresión a Archivos de Alergia e Inmunología Clínica hacer click aquí.
Recibido | Aceptado | Publicado 2009-04-01
Introducción
Las inmunodeficiencias primarias (IP) comprenden un grupo heterogéneo de más de 100 enfermedades hereditarias que se caracterizan por ausencia o disfunción de la respuesta inmune. Promueven infecciones graves, enfermedades autoinmunes, enfermedades alérgicas y mayor riesgo de cáncer en los pacientes afectados. La incidencia es de 1:10.000, es decir, frecuente y poco diagnosticada en los consultorios pediátricos. Aproximadamente el 50% de las IP son deficiencias de anticuerpos.
La deficiencia de anticuerpos con inmunoglobulinas normales se caracteriza por infecciones bacterianas recurrentes; ausencia o disminución de respuesta para la mayoría de los antígenos polisacáridos; niveles séricos normales o hasta poco elevados de inmunoglobulinas y de subclases de IgG y producción de anticuerpos adecuada ante los antígenos proteicos (sarampión, rubéola, etc.) en individuos mayores que 2 años. Todos los niños menores de 2 años presentan un defecto fisiológico en la respuesta a los antígenos de polisacáridos. El tratamiento se hace con antibioticoterapia profiláctica, vacunación antineumocócica y con inmunoglobulina humana [1-5].
Los primeros relatos de inmunodeficiencia de anticuerpos con inmunoglobulinas normales o discretamente disminuidas datan de los años 60. En Londres (1968), Blecher y cols. describieron el caso de una niña con infecciones a repetición que la llevó al óbito a los 17 meses de vida por bronconeumonía. Presentaba inmunoglobulinas normales, isohemaglutininas ausentes y sin respuesta a los antígenos de Salmonella typhi y S. paratyphi [6]. En los EE.UU. (1980), Saxon y cols. describieron el caso de un niño de 10 años que presentaba infecciones respiratorias a repetición, inmunoglobulinas normales, pero ausencia de respuesta a los antígenos O y H de la fiebre tifoidea y a los del virus de la poliomielitis [7]. Más tarde, Ambrosino y Sorensen describieron la deficiencia de producción de anticuerpos para gérmenes encapsulados (H. influenza, S pneumoniae, N. meningitidis, Branhamella catarrhalis) que pueden producir infecciones invasivas [1,2,10,15]. Los niños indios americanos y canadienses, los esquimales y los aleutas tienen mayor prevalencia de esta inmunodeficiencia con relación a otras razas, muchas veces, asociada a deficiencia de subclases de IgG [16-18]. Por eso presentan altos índices de infección invasiva por neumococo y por H. influenzae, además de alta resistencia a los antibióticos [2-16].
Cuadro clínico
El cuadro clínico puede variar ampliamente. Pueden ser asintomáticos o presentar infecciones a repetición de vías aéreas superiores (IVAS, otitis, laringitis, sinusitis y mastoiditis) e inferiores (bronquitis y neumonías). Presentan también diarreas crónicas, giardiasis recurrentes, osteomielitis, sepsis y meningitis. Son pacientes que utilizan exceso de antibióticos, profilácticos, curativos y pueden desarrollar resistencia bacteriana. Generalmente son adenoamigdalectomizados y, por la baja audición, son sometidos a tubos auditivos de ventilación sin mejoramiento del cuadro. La asociación de rinoconjuntivitis alérgica y asma atópica es frecuente y aumenta el riesgo de enfermedad neumocócica invasiva. Otras inmunodeficiencias (deficiencia de complemento; deficiencia de IgG2 [opsonización]; IgA; Wiskott-Aldrich; ataxia-telangiectasia; hiper IgM; asplenia congénita; etc.) pueden estar asociadas [11-14,19-30].
Los 10 signos de alerta (Fundación Jeffrey-Modell y Cruz Roja Americana) son útiles para el diagnóstico y están presentados en la Tabla 1.
Cuadro en laboratorio
El cuadro en laboratorio se caracteriza por niveles séricos de IgA, IgM, IgG y subclases de IgG generalmente normales o elevados. La respuesta de anticuerpos a los antígenos proteicos de vacunas como el sarampión, el tétano, la difteria, la paperas, etc. son normales. Las isohemaglutininas son normales. El diagnóstico se hace por la dosificación de anticuerpos IgG antipolisacáridos para S. pneumoniae o H. influenzae por el método ELISA. En nuestro medio la determinación se hace para los serotipos del neumocco (IgG antiPS 1, 3, 5 6B [tipo 26], 9V [tipo 68] y 14). El valor normal debe ser igual o mayor 1,3 mg/l en al menos 4 serotipos o la elevación de 4 veces más tras la vacunación. La técnica, en Brasil, es realizada en el ICB-USP y se detalla en el sitio www.imunopediatria.org (Figura 1). La vacunación deberá ser realizada con la vacuna antineumocócica 23-valente tras la colecta previa y esperar por 4 semanas para proceder a la colecta posvacuna [1,2,26,31-36].
S. pneumoniae y la infección
El S. pneumoniae es un diplococo Gram positivo (violeta de genciana + lugol), alfahemolítico, catalasa negativo por no liberar O2 de la reacción H2O2 y coagulasa negativo por no transformar fibrinógeno en fibrina. No pertenece a los grupos A, B y D de Lancefield, así como el S. viridans. Son más de 90 serotipos y algunos tipos clasificados por números y letras exhaustivamente estudiados.
Los mecanismos de adhesión, invasión, colonización, inflamación y choque son auxiliados por enzimas y proteínas de superficie del neumococo. La autolisina es responsable de la destrucción de la pared durante la división celular y de la liberación de la neumolisina del citoplasma. Ésta, a su vez, promueve hemólisis, inhibición de los macrófagos y neutrófilos respiratorios, inhibición de la actividad ciliar y apertura de las uniones estrechas (tight junctions) de las células de las vías aéreas, que facilita la invasión de los espacios peribronquiolares y perivasculares. La neuroaminidasa A y B está relacionada con la adhesión, la colonización y la invasión de los tejidos. La hialuronidasa degrada el tejido conectivo y está relacionada con la facilitación de la penetración del neumococo por la barrera hematoencefálica causando meningitis. Las proteínas de superficie, la PsaA (pneumococcal surface adhesin A) y la PspA (pneumococcal surface protein A) están relacionadas con la virulencia y la unión de la lactoferrina. La PspC (pneumococcal surface protein C) se relaciona con el transporte y, cuando está unida a la IgAs y al factor H (complemento), con la actividad antifagocítica [31-34].
La infección neumocócica es relativamente frecuente en niños menores de 5 años, inmunodeficientes y ancianos. Está presente en el 10 al 50% en la orofaringe de niños saludables, pero en los EE.UU. es responsable por 500.000 casos de neumonías, 7 millones de otitis, 3.000 casos de meningitis, 50.000 casos de septicemias y 40.000 defunciones cada año.
Los estudios nacionales demostraron del 20 al 40% de letalidad y el 40% de secuelas neurológicas en pacientes con meningitis neumocócica. La letalidad es mayor en pacientes menores de 2 años. Los serotipos encontrados fueron 1, 5, 6B, 14, 19A y 23F (el 70% existente en la vacuna conjugada 7-valente). En las neumonías, los serotipos 1, 5 y 14 son los más frecuentes (vacuna 23-valente). Los estudios epidemiológicos brasileños para evaluación de cepas de neumococos en orofaringe fueron realizados en guarderías y hospitales y, quizá, no correspondan a las cepas y a la virulencia de los gérmenes comunitarios [4,35-41].
Esta dualidad es explicada por las formas transparente y opaca de las colonias. En la forma transparente, las colonias tienen mayor poder de colonización, pero menor virulencia. Y en las colonias opacas, la pared es más gruesa, el poder de colonización es reducido y la virulencia está extremadamente aumentada (forma invasiva) [31]. La figura 2 muestra las colonias opacas y transparentes.
Tratamiento
El tratamiento deberá priorizar el combate riguroso a las infecciones, principalmente las invasivas. La antibioticoterapia profiláctica puede auxiliar en la calidad de vida de estos pacientes. Hasta ahora no existe un consenso sobre la medicación y la dosis ideal de antibióticos utilizados profilácticamente. En la práctica se emplean sulfametoxazol/trimetoprima, amoxacilina y azitromicina.
La gammaglobulina en las dosis habituales (400 a 600 mg/kg/dosis mensualmente) está indicada en los casos más graves. Algunos casos mejoran con 6 a 24 meses de reposición mientras que otros necesitan gammaglobulina permanente. Las evaluaciones de dosificaciones séricas de control solamente tienen validez tras 4 a 6 meses de discontinuidad de la gammaglobulina.
Una evaluación estricta en el calendario de vacunas de estos pacientes observando las vacunas del calendario oficial, como la vacuna anti-Haemophilus, es importante. La utilización de las vacunas 23-valente y 7-valente mejoran solamente los casos “respondedores”. No hay un consenso, hasta ahora, cuál es el porcentaje de “respondedores”. Hay referencias de que, en algunos casos, la revacunación podría proporcionar niveles de anticuerpos más protectores. Debemos recordar también que la vacuna 23-valente es ineficaz antes de los 2 años de vida por la imposibilidad del organismo de producir anticuerpos contra polisacáridos [8,23,32,39]. Las vacunas 9, 10, 11 y 13-valente aún no están disponibles.
Conclusiones
Estar alerta a los pacientes con infecciones a repetición, principalmente pacientes con infecciones neumocócicas, y realizar la evaluación complementaria en laboratorio para un correcto diagnóstico de la enfermedad.
Agradecimientos
Agradezco a los Profesores Cristina Miuki Abe Jacob, Antonio Carlos Pastorino, Cristina Arslanian y Mariana Ocenjo (ICr. y Laboratorio de Mucosas/USP) por las orientaciones recibidas.
-
Sorensen RU, Moore C. Immunology in the pediatrician`s office. Pediatr Clin North Am 1994;41(4):691-714.
-
Sorensen RU, Moore C. Antibody deficiency syndromes. Pediatr Clin North Am 2000;47(6):1225-52.
-
Stiehm ER, Ochs HD, Winkelstein JA. Antibody deficiency in: Ochs HD, Stiehm ER, Winkelstein JA. Immunologic Disorders in Infants & Children. Ed. Elsevier Saunders. 5ª edition. 2002. pp. 356-426.
-
Costa Carvalho BT, Carneiro-Sampaio MM, Solé D, Naspitz C, Leiva LE, Sorensen RU. Transplacental transmission of serotype-specific pneumococcal antibodies in a Brazilian population. Clin Diagn Lab Immunol 1999;6(1):50-4.
-
Ballow M. Primary immunodeficiency disorders: antibody deficiency. J Allergy Clin Immunol 2002;109(4):581-91.
-
Blecher TE, Soothill JF, Voyce MA, Walker WH. Antibody deficiency syndrome: a case with normal immunoglobulins levels. Clin Exp Immunol 1968;3:47-56.
-
Saxon A, Kobayashi RH, Stevens RH, Singer AD, Stiehm ER, Siegel SC. In vitro analysis of humoral immunity in antibody deficiency with normal immunoglobulins. Clin Immunol Immunopathol 1980;17:235-44.
-
Ashida ER, Saxon A. Home intravenous immunoglobulin therapy by self-administration. J Allergy Clin Immunol 1986;6(4):306-9.
-
French MA, Harrison G. Systemic antibody deficiency in patients without serum immunoglobulin deficiency or with selective IgA deficiency. Clin Exp immunol 1984;56(1):18-22.
-
Ambrosino DM, Siber GR, Chilmonczyk BA, Jernberg JB, Finberg RW. An immunodeficiency characterized by impaired antibody responses to polysaccharides. N Engl J Med 1987;316:790-93.
-
Gross S, Blaiss MS, Herrod HG. Role of immunoglobulin subclass and specific antibody determinations in the evaluation of recurrent infection in children. J Pediatr 1992;121:516-22.
-
Sanders LA, Rijkers GT, Kuis W. Defective antipneumococcal polysaccharide antibody response in children with recurrent respiratory tract infections. J Allergy Clin Immunol 1993;891:110.
-
Zora JA, Silk HJ, Tinkelman DG. Evaluation of postimmunization pneumococcal titers in children with recurrent infections and normal levels of immunoglobulin. Ann Allergy 1993;70:283-8.
-
Hidalgo H, Moore C, Leiva LE, Sorensen RU. Preimmunization and postimmunization pneumococcal antibody titers in children with recurrent infections. Ann Allergy 1996;76:341-6.
-
Sorenbsen RU, Hidalgo H, Moore C, Leiva LE. Post-immunization pneumococcal antibody titers and IgG subclasses. Pediatr Pulmonol 1996;22:167-173.
-
Ward J, Brenneman G, Letson GW, Heyward WL. Limited efficacy of a Haempphilus influenzae type b conjugate vaccine in Alaska native infants. New Engl J Med 1990;323(20):1393-1401.
-
Siber GR, Santosham M, Reid R, Thompson C, Almeido-Hill J, Morell A, deLange G, Ketcham JK, Callahan E. Impaired antibody response to Haemophilus influenzae type b polysaccharide and low IgG2 and IgG4 concentrations in Apache children. New Engl J Med 1990;323(20):1387-1392.
-
Moore MR, Hyde TB, Hennessy TW, Parks DJ, Reasonover AL, Harker-Jones M, Gove J, Bruden DL, Rudolph K, Parkinson A, Butler JC, Schuchat A. Impact of a conjugate vaccine on community-wide carriage of nonsusceptible Streptococcus pneumoniae in Alaska. J Infect Dis 2004;190:2031-8.
-
Costa-Carvalho BT, Cocco RR, Rodrigues WM, Colla VA, Sole D, Carneiro-Sampaio MM. Pneumonias de repetição em paciente com deficiência de anticorpos e imunoglobulinas normais. J Pneumol 2002;28(3)155-8.
-
Costa-Carvalho BT, Nagao AT, Arslanian C, Carneiro-Sampaio MM, Naspitz CK, Sorensen RU, Leiva L, Solé D. Immunological evaluation of allergic respiratory children with recurrent sinusitis. Pediatr Allergy Immunol 2005;16(6):534-8.
-
Gerra-Maranhão MC, Costa-Carvalho BT, Nudelman V, Barros-Nunes P, Carneiro-Sampaio MMS, Arslanian C, Nagao-Dias AT, Sole D. Resposta a antígenos polissacarídicos em pacientes com ataxia-telangiectasia. J Pediatr (Rio de J) 2006;82(2):132-6.
-
Sanal O, Ersoy F, Tezcan I, Metin A, Turul T, Garibogiu S, Yel L. Antibody response to a seven-valent pneumococcal conjugated vaccine in patients with ataxia-telangiectasia. J Clin Immunol 2004;24(4):411-17.
-
Molrine DC, Siber GR, Samra Y, Shevy DS, MacDonald K, Cieri R, Ambrosino DM. Normal IgG and impaired IgM responses to polysaccharide vaccines in asplenic patients. J Infect Dis 1999;179:513-17.
-
Pinto J. Evaluation of humoral immune response. Clinics 2005;60(Suppl. 1):S1-S4.
-
Notarangelo L, Casanova JL, Conley ME, Chapel H, Fischer A, Puck J, Roifman C, Seger R, Geha RS. Primary immunodeficiency diseases: Na update from the international union of immunological societies primary immunodeficiency diseases classification committee meeting in Budapest, 2005. J Allergy Clin Immunol 2006;117:883-96.
-
Kirkpatrick CH. Specific polysaccharide antibody deficiency (Editorial). Ann Allergy Asthma Immunol 2006;97(3):271.
-
Shapiro GG, Virant FS, Furukawa CT, Pierson WE, Bierman W. Immunologic defects in patients with refractory sinusitis. Pediatrics 1991;87(3):311-15.
-
Ambrosino DM, Umetsu DT, Siber GR, Howie G, Goulart TA, Michaels R, Martin P, Schur PH, Noyes J, Schiffman G, Geha RS. J Allergy Clin Immunol 1988;81:1175-9.
-
Talbot TR, Hartert TV, Mitchel E, Halasa NB, Arbogast PG, Poehling KA, Schffner W, Craig AS, Griffin MR. Asthma as a risk factor for invasive pneumococcal disease. N Engl J Med 2005;352(20):2082-90.
-
Petti CA, Ignatius Ou SH, Sexton DJ. Acute terminal ileitis associated with pneumococcal bacteremia: case report and review of pneumococcal gastrointestinal diseases. Clin Infect Dis 2002;34(10):E50-3.
-
Gillespie SH, Balakrishnan I. Pathogehesis of pneumococcal infection. J Med Microbiol 2000;49:1057-67.
-
Barreto DG, Rodríguez RS, Jaimes EC, Espinosa LE. Bases fisiopatológicas para la prevención d alas infecciones por Streptococcus pneumoniae. Bol Med Hosp Infant Mex 2001;58(12):866-78.
-
Pimenta FC, Ribeiro-Dias F, Brandileone MC, Miyaji MCC, Leite EN, Sgambatti de Andrade AL. Genetic diversity of PspA types among nasopharyngeal isolates collectd during na ongoing surveillance study of children in Brazil. J Clin Microbiol 2006;44(8):2838-43.
-
Dave S, Carmicle S, Hammerschmidt S, Pangburn MK, McDaniel LS. Dual roles of PspC, a surface protein of Streptococcus pneumoniae, in binding human secretory IgA and factor H. J immunol 2004;173(1):471-7.
-
Hortal M, Ruvinsky R, Rossi A, Agudelo CI, Castañeda E, Brandileone C, Camou T, Palácio R, Echaniz G, Di Fabio JL. Impacto de Streptococcus pneumoniae em las neumonias del niño latinoamericano. Grupo SIREVA-Vigia. Rev Panam Salud Publica 2000;8(3):185-94.
-
Ferreira LLM, Carvalho ES, Berezin EM, Brandileone MC. Colonização e resistência antimicrobiana de Streptococcus pneumoniae isolado em nasofaringe de crianças com rinofaringite aguda. J Pediatr (Rio de J) 2001;77(30):227-34.
-
Berezin EM, Carvalho LH, Lopes CR, Sanajotta AT, Brandileone MCC, Menegatti S, Safadi MA, Gerra MLCS. Meningite pneumocócica na infância: características clínicas, sorotipos mais prevalentes e prognóstico. J Pediatr (Rio de J) 2002;78(1):19-23.
-
Carvalho CE, Berezin EM, Pistelli IP, Mímica L, Cardoso MRA. Monitoramento microbiológico seqüencial da secreção traqueal em pacientes intubados internados em unidade de terapia intensiva pediátrica. J Pediatr (Rio de J) 2005;81(1):29-33.
-
Lucarevischi BR, Baldacci ER, Bricks LF, Bertoli CJ, Teixeira LM, Mendes CMF, Oplustil C. Colonização de orofaringe por Streptococcus pneumoniae em crianças de creches municipais de taubaté-SP: correlação entre os principais sorotipos e a vacina pneumocócica conjugada heptavalente. J Pediatr (Rio J) 2003;79(3):215-20.
-
Rodrigues JC, Silva Filho LVF, Bush A. Diagnóstico etiológico das pneumonias - uma visão crítica. J Pediatr (Rio J) 2002;78(supl.2):S129-40
-
Carneiro-Sampaio M, Coutinho A. Immunity to Microbes: Lessons from Primary Immunodeficiêncies. Infect Immun 2007;75(4):1545-55.
Orlei Kantor Junior
Médico neumopediatra del PAG-Pediatría. Hospital de Clínicas / UFPR. Curitiba. Brasil, PR. Maestro en Pediatría.
Autor correspondencia
Orlei Kantor Junior
Médico neumopediatra del PAG-PediatrÃa. Hospital de ClÃnicas / UFPR. Curitiba. Brasil, PR. Maestro en PediatrÃa.
Correo electrónico: orleikantorjr@ufpr.br
Para descargar el PDF del artículo
Deficiencia de anticuerpos con inmunoglobulinas IgA, IgG e IgM normales
![]() Haga click aquí
Haga click aquí
Para descargar el PDF de la revista completa
Archivos de Alergia e Inmunología Clínica , Volumen Año 2009 Num 1
Archivos de Alergia e Inmunología Clínica
Número 1 | Volumen
40 | Año 2009
Hipersensibilidad a los antiinflama...
César M Bózzola y cols.
Deficiencia de anticuerpos con inmu...
Orlei Kantor Junior
Prevalencia y características clí...
Marcelo D Strass
Estudio comparativo de la morbilida...
C Carignano y cols.
Comentario sobre: Pruebas cutáneas...
Natalia L Cochet
Etiquetas
inmunodeficiencia primaria, deficiencia de anticuerpos, infección neumocócica
Tags
primary immunodeficiency, antibody deficiency, pneumococcal infection
Deficiencia de anticuerpos con inmunoglobulinas IgA, IgG e IgM normales
Autores
Orlei Kantor Junior
Publicación
Archivos de Alergia e Inmunología Clínica
Editor
Asociación Argentina de Alergia e Inmunología Clínica
Fecha de publicación
2009-04-01
Registro de propiedad intelectual
© Asociación Argentina de Alergia e Inmunología Clínica